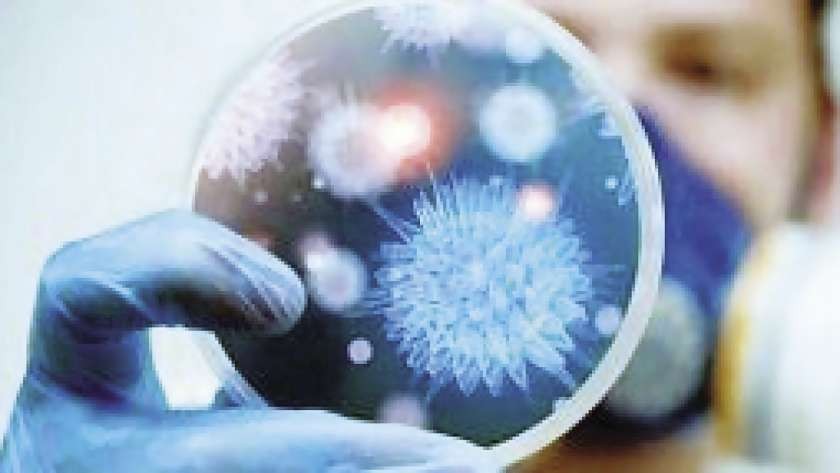

أعلنت وزارة الصحة في إقليم كردستان العراق، تسجيل 6 إصابات جديدة بفيروس كورونا المستجد “كوفيد 19″، جميعها في محافظة السليمانية.
وذكرت وزارة الصحة في إقليم كردستان العراق، في بيان أوردته الوكالة الوطنية العراقية للأنباء اليوم، أنه خلال الساعات الـ24 الماضية، تم إجراء 178 فحصاً موزعاً على أربيل 27 فحصاً، والسليمانية 64 فحصاً، ودهوك 87 فحصاً.
وأضافت الوزارة الكردية، أن نتيجة الفحوصات كانت تسجيل 6 إصابات جديدة بالسليمانية، وهم 5 رجال بأعمار 23 و25 و40 و40 و70 عاماً، إلى جانب امرأة تبلغ 24 عاماً.